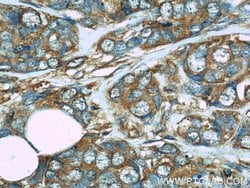
FHIT Mouse anti-Human, Clone: 4D6G1, Proteintech 150 &mu;L; Unconjugated:Antibodies,

missing translation for 'onlineSavingsMsg'
Learn More
Learn More
FHIT Mouse anti-Human, Clone: 4D6G1, Proteintech
Mouse Monoclonal Antibody
Brand: Proteintech 66086-1-IG-150UL
This item is not returnable.
View return policy
Description
Alterations and deletions of the FHIT gene are strongly linked to the genesis and establishment of human tumors of the lung, cervix, breast, colon, stomach and pancreas. In normal cells, FHIT may act as a tumor suppressor.Specifications
| FHIT | |
| Monoclonal | |
| 0.67 mg/mL | |
| PBS with 50% glycerol and 0.02% sodium azide; pH 7.3 | |
| P49789 | |
| FHIT | |
| FHIT Fusion Protein Ag14471 | |
| 150 μL | |
| Primary | |
| Human | |
| Antibody | |
| IgG1 |
| Immunocytochemistry, Immunofluorescence, Immunohistochemistry (Paraffin), Western Blot | |
| 4D6G1 | |
| Unconjugated | |
| FHIT | |
| AP3A hydrolase, AP3Aase, Bis(5 adenosyl) triphosphatase, Dinucleosidetriphosphatase, FHIT, FRA3B, fragile histidine triad gene | |
| Mouse | |
| Protein A | |
| RUO | |
| 2272 | |
| -20°C | |
| Liquid |
Product Content Correction
Your input is important to us. Please complete this form to provide feedback related to the content on this product.
Product Title
Spot an opportunity for improvement?Share a Content Correction